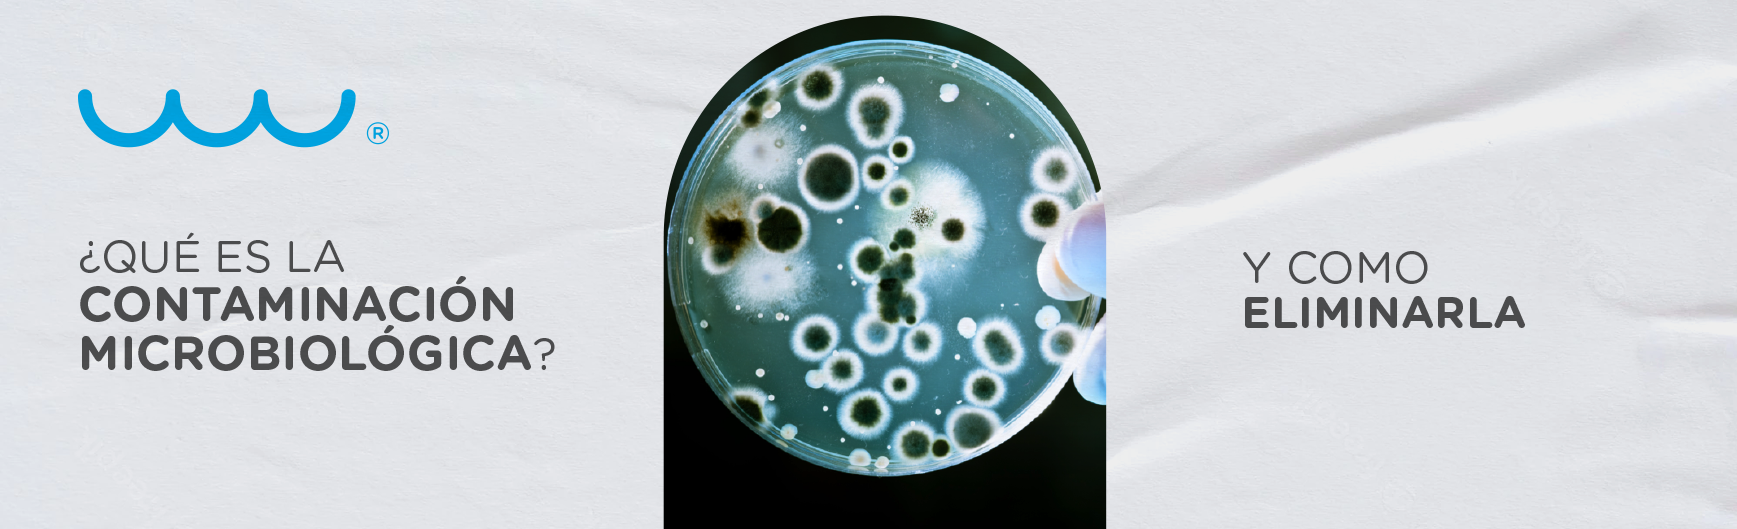

Categorías
-
Filtros de agua 59
-
Línea de laboratorio 35
-
Línea Proceso 16
-
Noticias Water Technologies 1
-
Nuevos Proyectos 17
-
Purificador de agua 133
-
Todos 261
Publicaciones - Todos

¿Cómo el tratamiento de agua industrial puede mejorar la eficiencia y productividad en tu empresa?
Purificador de agua
21 de Junio, 2023

¿Dónde se utiliza un filtro purificador de agua?
Filtros de agua
19 de Junio, 2023

Mejora la calidad de tu agua con la última innovación.
Purificador de agua
14 de Junio, 2023

Cómo elegir un filtro de agua: Todo lo que necesitas saber para tomar la mejor decisión.
Filtros de agua
12 de Junio, 2023

Ultrafiltración vs Ósmosis Inversa: La diferencia clave en el tratamiento de agua.
Purificador de agua
08 de Junio, 2023

¿Sabías que las membranas de ósmosis inversa son el corazón del sistema de tratamiento de agua?
Filtros de agua
06 de Junio, 2023

¿Por qué elegir una Válvula Clack?
Purificador de agua
27 de Marzo, 2023

Agua tratada para riego.
Purificador de agua
24 de Febrero, 2023

¿Cuáles son los beneficios de un sistema de ósmosis inversa en restaurantes?
Purificador de agua
26 de Enero, 2023

¿Qué es la sal para suavizador de agua?
Purificador de agua
14 de Diciembre, 2022
¿Qué es la contaminación microbiológica y cómo eliminarla?
Purificador de agua
24 de Noviembre, 2022

Conoce los métodos de tratamiento de agua con los que contamos.
Purificador de agua
13 de Octubre, 2022

Características estructurales de las Bombas Centrífugas.
Purificador de agua
26 de Julio, 2022

¿Qué son los filtros industriales para agua?
Purificador de agua
23 de Junio, 2022

¿Qué son viales de DQO?
Línea de laboratorio
13 de Mayo, 2022

¿Por qué elegir Resina Purolite para suavizar el agua?
Filtros de agua
24 de Marzo, 2022

¿Qué son las incrustaciones?
Línea de laboratorio
21 de Febrero, 2022

¿Qué beneficios tienen los sensores de desinfección amperométricos de Walchem?
Purificador de agua
18 de Noviembre, 2021

¿Sabías que nuestro proyecto Danone se utilizó para la elaboración de leche silk?
Nuevos Proyectos
27 de Octubre, 2021

¡Determine la concentración con un método de comparación visual utilizando los kits de discos de color!
Línea de laboratorio
15 de Octubre, 2021